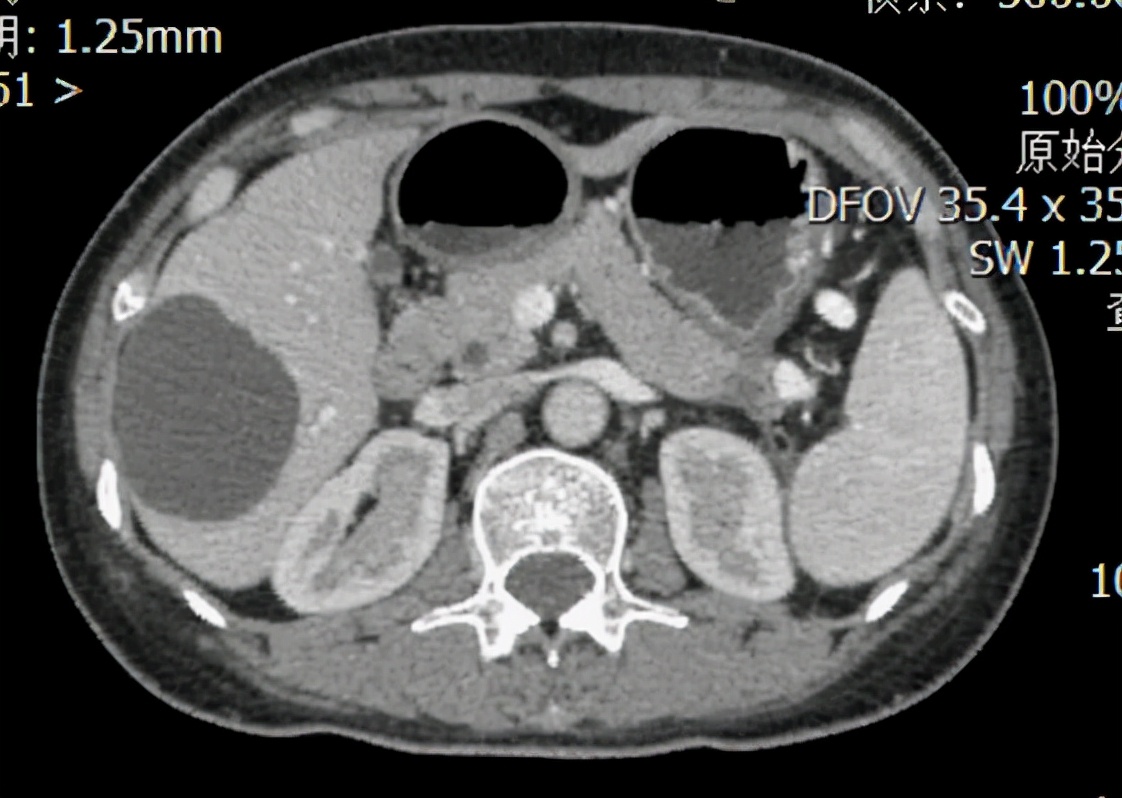
胰腺腺鳞癌手术后能生存几年,胰腺腺癌与胰腺鳞癌

【基本信息】52岁、女性
【疾病类型】胰腺原发性鳞癌
【治疗医院】中国医学科学院肿瘤医院深圳医院
【治疗方案】紫杉醇(白蛋白结合型)+顺铂化疗后手术切除肿瘤
【治疗周期】6个月
【治疗效果】肿瘤完全消失,并获得手术根治性切除机会
在我的门诊,我每日可能会看到很多胰腺癌的患者,但是病理分型为原发性鳞癌患者的确特别少见,所以有些患有此种病理类型的患者我格外的记忆犹新,这是一位中年老师,这类罕见肿瘤降临到了她的身上,辗转于深圳多家三甲医院,已经被确诊为晚期,没有医生敢给予治疗。我的门诊是她的最后一站,看着她焦急的面容,我犹豫了,毕竟这个肿瘤类型恶性程度极高,平均存活时间不超6个月,但是我认为应该帮一下她,可能除了我以外没人会帮她了。“我们试一下吧,虽然机会不大,但请相信我们。”我目光坚定的给予了答复。
一、初识患者
这是一位52岁的中年女患者,因右中上腹部疼痛伴反酸、烧心5月余,先后于深圳市西丽医院、罗湖区人民医院就诊,未能明确诊断,2018年6月至深圳市某人民医院就诊,行腹部彩超提示胰腺尾部占位,肝脏多发结节;2018-6-5*警武**医院PET-CT提示:胰腺尾部占位,大小6×7cm cm,侵犯胃后壁及左肾上腺,恶性肿瘤可能性大,腹膜转移瘤可能,肝脏多发转移可能。2018-6-14于中山大学附属第七医院行超声内镜引导下胰尾穿刺活检,病理回报:胰尾鳞状细胞癌。初步诊断:1、胰腺尾部鳞状细胞癌(cT4N1M1)2、肝多发转移瘤3、多发淋巴结转移。
二、 患者的治疗过程
转化治疗:
入院后完善相关影像学检查及病理会诊,再一次明确病理诊断及分期无误,切取肿瘤穿刺组织行基因检测,发现BRCA2体细胞突变,经多学科会诊,制定全身治疗方案为紫杉醇(白蛋白结合型)联合顺铂,经过10个周期规律化疗,复查影像学提示肝转移瘤、全身淋巴结转移瘤和腹膜转移瘤均已消失,胰腺原发灶较前明显缩小,直径约1cm。
手术治疗:
患者经过精准化疗,肿瘤治疗效果明显,堪称世界首例,这个时候手术与否是存在争议的,患者家属也走访了北京、上海、广州等顶级医院咨询,支持手术的医生与反对手术的医生各占一半,经过科室的认真讨论以后,决定手术切除胰腺原发灶及肝残留病灶。
手术后:
手术非常成功,手术后3天开始进食,7天后拔除引流管,基本恢复自主生活能力。
后续治疗:
鉴于该肿瘤为晚期转化成功,后续使用奥拉帕尼联合帕博丽珠单抗维持治疗。

图1:患者2018年6月的CT图,红框为胰腺尾部原发灶,大小约6×7cm。
图2:患者化疗9周期后的CT图,红框为胰腺尾部原发灶,直径约1cm。
三、医生感悟
此例肿瘤是极度恶性的罕见肿瘤,目前全世界正式报道的病例数不超1000例,而本例的治疗情况是世界首例转化成功的成功案例,堪称经典。医生在本例的治疗中充当了非常重要的作用,全面收集文献证据,小心判断病情,大胆创新,冒险行手术一搏,优秀的手术技术保证了术后的快速康复,基于基因检测证据的辅助治疗为手术巩固了效果。如果没有一颗医者仁心和高度负责的精神,这个患者的治疗可能无法获得这么巨大的成功。
本文由车旭、黄小准共同创作。